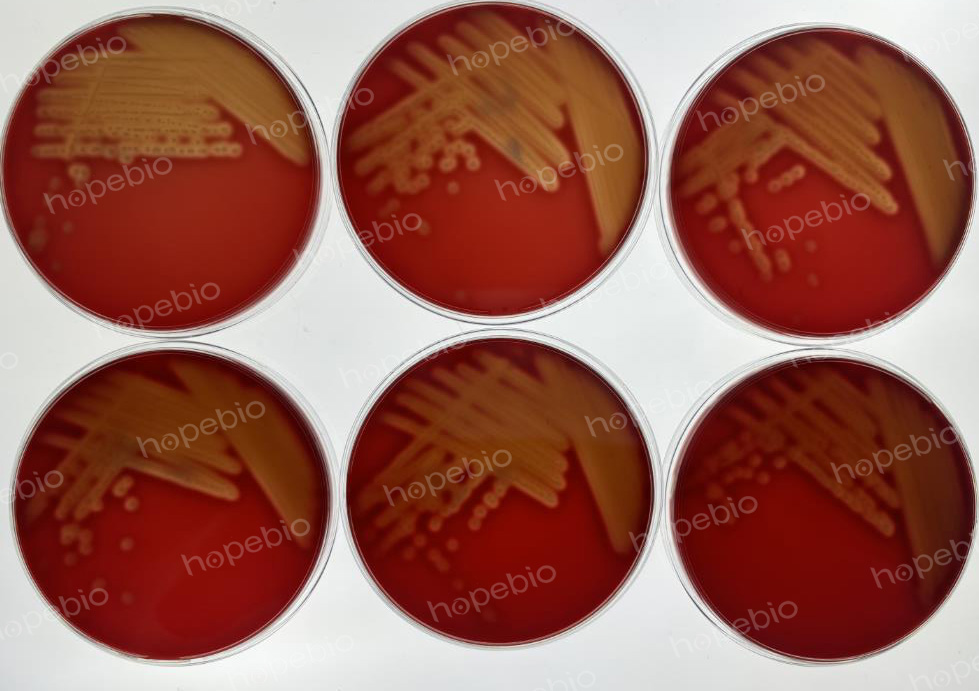
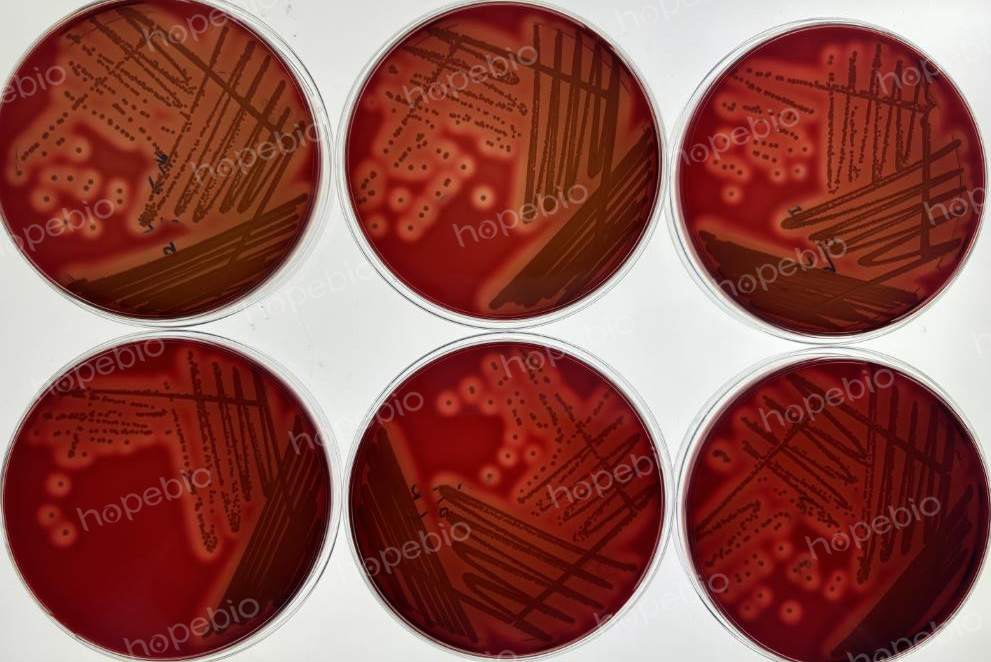
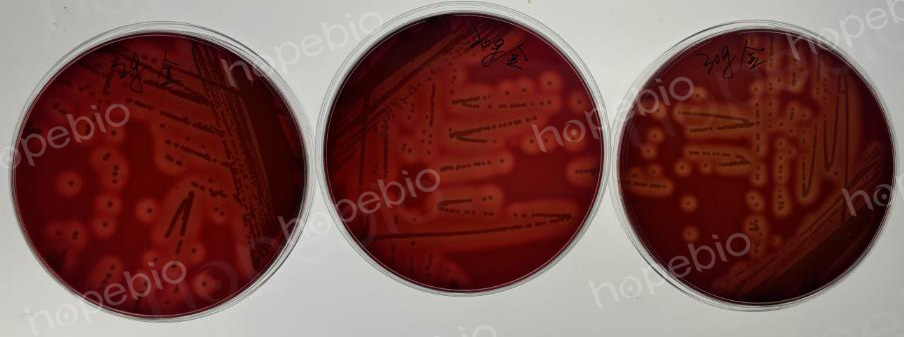
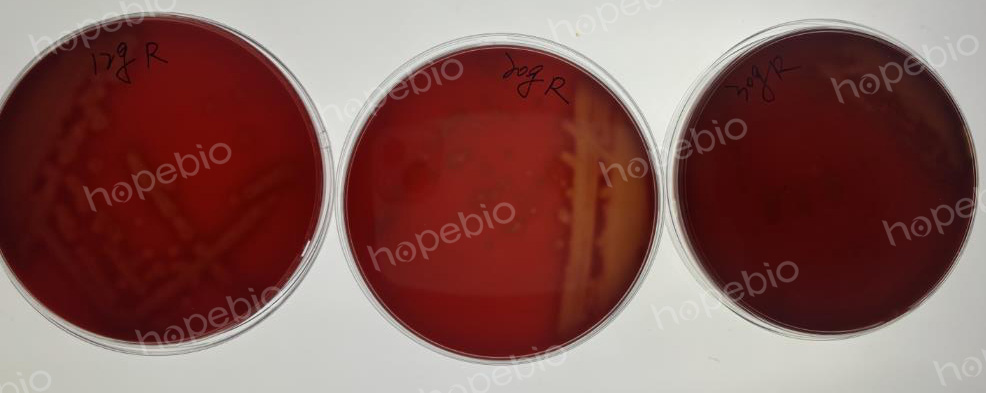
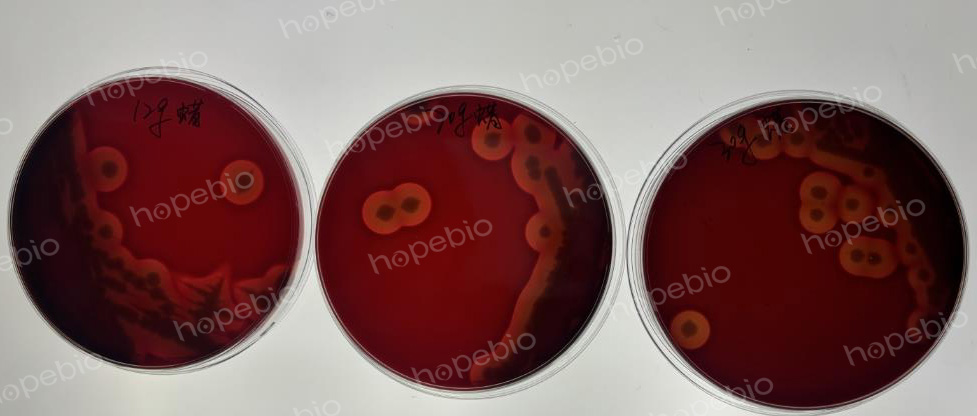

海博微信公众号
海博微信公众号
 海博天猫旗舰店
海博天猫旗舰店


 海博微信公众号
海博微信公众号
 海博天猫旗舰店
海博天猫旗舰店




一、血平板简介
血平板是常用的微生物培养平板之一,可以由TSA、营养琼脂、豆粉琼脂、哥伦比亚琼脂、脑心浸液琼脂等多种基础类营养培养基添加血液制成,其目的是添加的血液可以极大提高培养基的营养,对于一些营养苛求型细菌可以更容易培养成功。除此之外,观察细菌的溶血效果也是血平板的主要功能之一,为了获得较好的溶血效果,血平板通常会选用脱纤维绵羊血进行制备,羊血的添加比例一般为5%-10%。
二、血液浓度对溶血效果的影响
本实验首先测试了添加5%-10%的血液制成的血平板,不同菌株的溶血效果测试。试验结果表明,对于强β溶血效果的蜡样芽孢杆菌的溶血效果没有显著差异,对于α溶血效果的肺炎链球菌液没有显著差异,但对于β溶血的金黄色葡萄球菌(ATCC6538)和β溶血的乙型溶血性链球菌(CMCC32210)还是有微弱差别的,血液添加的浓度比例越高,溶血越慢,但差距并不大,虽然5%的比例可以更快溶血,但是制成的平板血色偏浅,稍偏透明,10%的比例则溶血效果明显更慢一些,因此建议配制时添加7%左右的脱纤维羊血即可(羊血本身浓度可能也存在微小差别,可以根据实际情况做出调整)。
乙型溶血性链球菌的溶血效果比对(上方从左至右分别为5%、6%、7%羊血琼脂平板,下方从左至右分别为8%、9%、10%羊血琼脂平板)。
金黄色葡萄球菌的溶血效果比对(上方从左至右分别为5%、6%、7%羊血琼脂平板,下方从左至右分别为8%、9%、10%羊血琼脂平板)
三、凝胶强度对溶血效果的影响
实验测试了12g/L、20g/L、30g/L的血琼脂上产生β溶血的蜡样芽胞杆菌、金黄色葡萄球、乙型溶血性链球菌的溶血效果测试,结果表明,培养基的琼脂量越多,凝胶强度越大,菌落产生的溶血环就会相对偏小。
金黄色葡萄球菌(从做至右分别为12g/L、20g/L、30g/L琼脂含量的血平板)
乙型溶血性链球菌(从做至右分别为12g/L、20g/L、30g/L琼脂含量的血平板)
蜡样芽胞杆菌(从做至右分别为12g/L、20g/L、30g/L琼脂含量的血平板)
相关产品:
哥伦比亚琼脂(USP)(Columbia agar)-点击查看产品详情
上一篇:洁净区沉降菌监测的要点
| 相关文章: | ||



